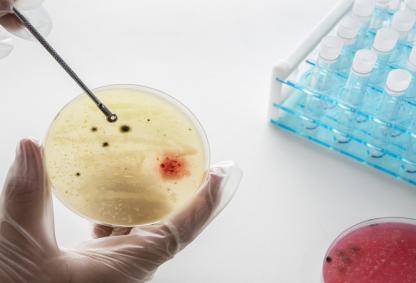
Image from Freepix

Announcements
Latest News







































Events Calendar
Faculty*
1000+
Students
13,000+
Publications
3,500+
Patents*
450+
Projects*
2,800+
*Faculty: 749 and 282 others
*Patents Published: 143 and Patents Granted: 325
*Total sponsored projects: 1583, Total consultancy projects: 1263
Life at IIT Bombay




















![An image of concrete tetrapods used as wave breakers to prevent beach erosion. [Credits: Pexels]](/sites/www.iitb.ac.in/files/styles/research_highlights_cards_/public/2025-11/pic1_2.jpg?itok=fEav3GhY)

![Simulated electromagnetic (EM) emission from accreting binary massive black hole during the late inspiral phase. [NASA/GSFC]; Credits: https://svs.gsfc.nasa.gov/13086/](/sites/www.iitb.ac.in/files/styles/research_highlights_cards_/public/2025-05/pic1_3.jpg?itok=-2u-_0v3)























































